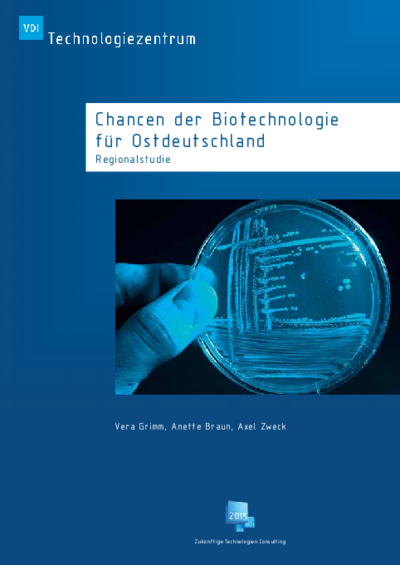

Chancen der Biotechnologie für Ostdeutschland
Auf einen Blick
- Ausgabedatum
- 2010-01
- Typ
- Regionalstudie
- Herausgeber
- Zukünftige Technologien Consulting der VDI Technologiezentrum GmbH
- Beschreibung
-
Neue Impfstoffe, Pflanzenzüchtungen zur Entgiftung belasteter Böden oder Reinigungsmittel für Abwässer: Die Biotechnologie ist eine der zukunftsträchtigsten Schlüsseltechnologien des 21. Jahrhunderts. Die ostdeutschen Bundesländer verfügen nicht nur über eine vielfältige Infrastruktur in diesem Bereich, sondern auch über gut vernetzte Akteure aus Forschung und Industrie. Herausforderungen ergeben sich vor allem bei der Einwerbung von privaten Finanzmitteln sowie dem Technologietransfer. Zu diesem Ergebnis kommt unsere jüngste Studie.
- Ansprechperson
-
VDI Technologiezentrum GmbH
Dr. Vera Grimm
E-Mail: grimm@vdi.de - Relevante Links
- Stichworte
- Biotechnologie